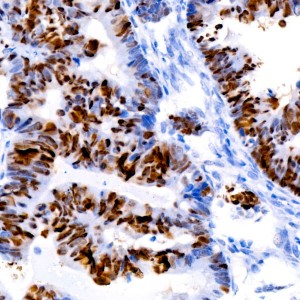
KO-Validated p53 Rabbit mAb (20 μl)

| Reactivity: | Human, Rat |
| Applications: | WB, IHC, IF/IC, ELISA |
| Host Species: | Rabbit |
| Isotype: | IgG |
| Clonality: | Monoclonal antibody |
| Gene Name: | Tumor protein p53 |
| Gene Symbol: | TP53 |
| Synonyms: | P53; BCC7; LFS1; BMFS5; TRP53; 53 |
| Gene ID: | 7157 |
| UniProt ID: | P04637 |
| Clone ID: | 8Y2K7 |
| Immunogen: | Recombinant fusion protein containing a sequence corresponding to amino acids 1-393 of human p53 (NP_000537.3). |
| Dilution: | WB 1:30000-1:120000 |
| Purification Method: | Affinity purification |
| Concentration: | 0.8 mg/ml |
| Buffer: | PBS with 0.05% proclin300, 0.05% BSA, 50% glycerol, pH7.3. |
| Storage: | Store at -20°C. Avoid freeze / thaw cycles. |
| Documents: | Manual-TP53 monoclonal antibody |
Background
This gene encodes a tumor suppressor protein containing transcriptional activation, DNA binding, and oligomerization domains. The encoded protein responds to diverse cellular stresses to regulate expression of target genes, thereby inducing cell cycle arrest, apoptosis, senescence, DNA repair, or changes in metabolism. Mutations in this gene are associated with a variety of human cancers, including hereditary cancers such as Li-Fraumeni syndrome. Alternative splicing of this gene and the use of alternate promoters result in multiple transcript variants and isoforms. Additional isoforms have also been shown to result from the use of alternate translation initiation codons from identical transcript variants (PMIDs: 12032546, 20937277).
Images
 | Western blot analysis of lysates from wild type(WT) and p53 knockout (KO) 293T(KO) cells, using [KO Validated] p53 Rabbit mAb (A22449) at 1:1000 dilution. Secondary antibody: HRP-conjugated Goat anti-Rabbit IgG (H+L) (AS014) at 1:10000 dilution. Lysates/proteins: 25μg per lane. Blocking buffer: 3% nonfat dry milk in TBST. Detection: ECL Basic Kit (RM00020). Exposure time: 60s. |
 | Immunohistochemistry analysis of paraffin-embedded Human oophoroma using [KO Validated] p53 Rabbit mAb (A22449) at dilution of 1:50 (40x lens). High pressure antigen retrieval performed with 0.01M Citrate Bufferr (pH 6.0) prior to IHC staining. |
 | Confocal imaging of A-431 cells using [KO Validated] p53 Rabbit mAb (A22449, dilution 1:200) followed by a further incubation with Cy3 Goat Anti-Rabbit IgG (H+L) (AS007, dilution 1:500) (Red). The cells were counterstained with α-Tubulin Mouse mAb (AC012, dilution 1:400) followed by incubation with ABflo® 488-conjugated Goat Anti-Mouse IgG (H+L) Ab (AS076, dilution 1:500) (Green). DAPI was used for nuclear staining (Blue). Objective: 100x. |
 | Confocal imaging of HT-29 cells using [KO Validated] p53 Rabbit mAb (A22449, dilution 1:200) followed by a further incubation with Cy3 Goat Anti-Rabbit IgG (H+L) (AS007, dilution 1:500) (Red). The cells were counterstained with α-Tubulin Mouse mAb (AC012, dilution 1:400) followed by incubation with ABflo® 488-conjugated Goat Anti-Mouse IgG (H+L) Ab (AS076, dilution 1:500) (Green). DAPI was used for nuclear staining (Blue). Objective: 100x. |
You may also be interested in: